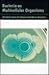

Books by Martin M. Dworkin

Martin M. Dworkin
Average rating 5.00 · 10 ratings · 0 reviews · shelved 43 times
Average rating 5.00 · 10 ratings · 0 reviews · shelved 43 times
Showing 11 distinct works.

|
The Prokaryotes: Vol. 4: Bacteria: Firmicutes, Cyanobacteria
by
—
published
2006
—
19 editions
|
|

|
The Prokaryotes: Vol. 1: Symbiotic Associations, Biotechnology, Applied Microbiology
by
—
published
2006
—
5 editions
|
|

|
The Prokaryotes: Vol. 2: Ecophysiology and Biochemistry
by
—
published
2005
—
4 editions
|
|

|
The Prokaryotes: Vol. 3: Archaea. Bacteria: Firmicutes, Actinomycetes
by
—
published
2005
—
3 editions
|
|

|
The Prokaryotes: Vol. 5: Proteobacteria: Alpha and Beta Subclasses
by
—
published
2005
—
3 editions
|
|

|
Myxobacteria II
by
—
published
1993
|
|

|
Microbial Cell-Cell Interactions
by
—
published
1991
|
|

|
Developmental Biology of the Bacteria
by
—
published
1986
|
|

|
The Prokaryotes: Vol. 7: Proteobacteria: Delta and Epsilon Subclasses. Deeply Rooting Bacteria
by
—
published
2005
—
5 editions
|
|

|
THE VANISHING DIARY OF ANNE FRANK - article in one issue of BLACKFRIARS January 1964
by |
|
|
Bacteria as Multicellular Organisms
by
—
published
1997
—
2 editions
|
|
* Note: these are all the books on Goodreads for this author. To add more books, click here.

